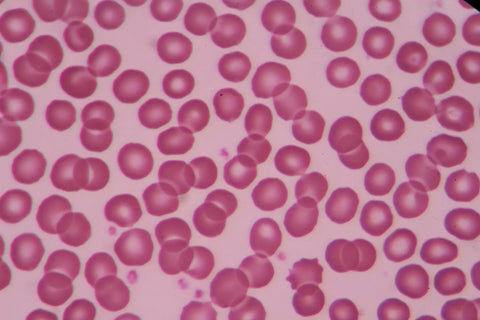

Cardiovascular

B-12 COVID-19 Deficiencies Fertility / Pregnancy / Women's Health Health Issues Kid's Health Mental Health Methylfolate Facts MTHFR Genetics News Resources Staying Healthy Super-B-Complex This study aimed to investigate the potential parameters associated with imaging progression on chest CT from coronavirus disease 19 (COVID-19) patients.

Studies show that supplementing with folate (vitamin B9) while pregnant may help prevent a wide range of birth defects, including congenital heart defects.
B-12 COVID-19 Deficiencies Fertility / Pregnancy / Women's Health Health Issues Kid's Health Mental Health Methylfolate Facts MTHFR Genetics News Resources Staying Healthy Super-B-Complex Homocysteine is a common amino acid (aka the “building blocks of proteins”) in your blood.

The COVID-19 pandemic has caught the whole world by surprise. Suddenly our lives took a 180 degree turn. We are learning to get used to what people call “the new normal”.

Learn about the relationship between folate, vitamin B6, vitamin B12 intake, and hyperuricemia at Methyl-Life. Gain insights into managing uric acid levels through balanced nutrition for optimal health.